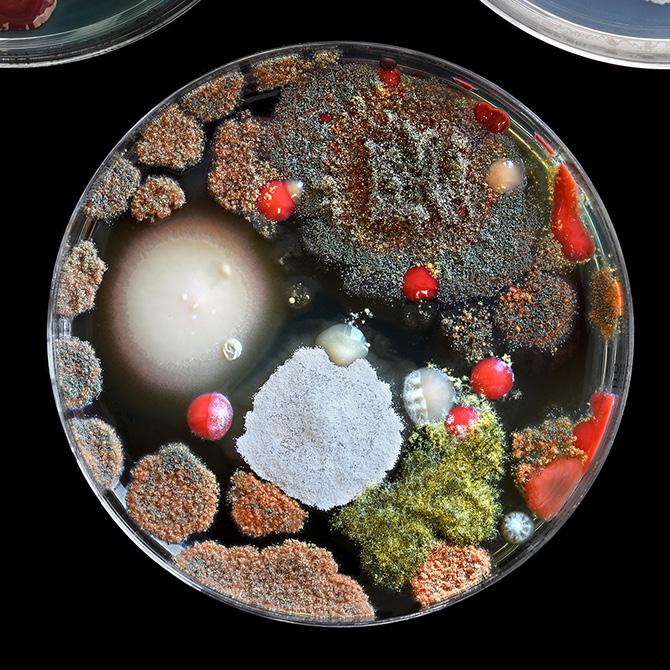
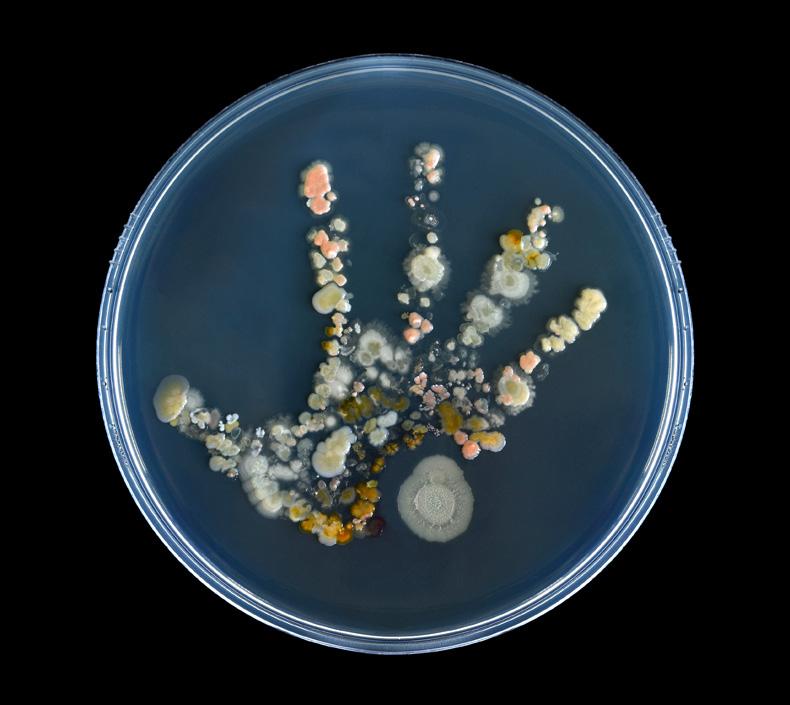

Jannicke
Wiik-Nielsen | Sarah Herlofsen




Wiik-Nielsen | Sarah Herlofsen


Du består av 37 tusen milliarder levende byggeklosser – små celler som jobber dag og natt. De gjør at du kan danse, løpe, drømme og snakke. Når de samarbeider, lager de alt fra fingernegler og øyevipper til følelser som kjærlighet, glede og sinne.
Bli med å utforske denne utrolige verdenen. Her blir du kjent med cellene og organene, og finner ut hvordan de samarbeider for å bygge og vedlikeholde et ekte underverk: deg.
Ved å bruke ulike teknikker som tar bilder av innsiden av mennesker er det mulig å få et helt spesielt innblikk i kroppen. Bildene i boken er tatt på sykehus, klinikker og forskningsinstitusjoner her i Norge.
Er du klar for å ta en nærmere titt på en av verdens mest imponerende skapninger?
Bli med å se tett på mennesket.

ET LIV BLIR TIL 8
En livsfarlig reise 11
BUDSKAP FRA VERDEN 16
Hjernen 18
Synet 26
Lukt og smak 30
Hørselen 34
Føle med hud og hår 38
HVORDAN ALT HENGER PÅ GREIP 46
Skjelettet 48
Tenner 52

Musklene 60
FRA TOPP TIL TÅ UTEN PAUSE 66
Hjertet 68
Lungene 72
Magen 76
Tynn- og tykktarmen 82
Leveren 92
Nyrene 98

ALDRI ALENE 102
Virus 104
Bakterier 108
Sopp 114
MIKROBENE GJØR OPPRØR 120

TEKNIKKENE 123
Takk 131
Kilder 133
Livet starter med to ganske forskjellige celler som redder hverandre fra den sikre død. Mannens sædcelle er den minste cellen i menneskekroppen. Med lang hale svømmer den gjennom mørke og kronglete tunneler i kvinnekroppen på jakt etter eggcellen. Man skulle tro at den var ganske lett å finne, for eggcellen er den aller største cellen i kroppen. Den kan ses uten mikroskop. Men sædcellenes reise til egget er full av farer.
En mann lager flere hundre milliarder sædceller i løpet av livet. Det er nok til å befolke hele jordkloden — og noen ekstra planeter. En kvinne fødes med 1—2 millioner egg. De fleste av dem blir aldri brukt. Bare rundt 300—400 egg modnes og kan bli befruktet i løpet av livet.
Sædceller – forstørret 10 000 ganger. ►


De fleste sædcellene går seg vill eller dør. Av de mange millionene som begynner reisen, er det kun noen få som er raske og utholdende nok til å snike seg forbi alle hindrene – gjennom labyrinten og frem til eggcellen.
Sædcellene kaster seg over eggcellen, som daler majestetisk ned egglederen. Eggcellen slipper bare inn én eneste av de små sædcellene. Når de to cellene smelter sammen, er det ikke slutten på eventyret. Det er bare begynnelsen.
Det er ikke så lett å forstå hvordan et helt menneske med harde knokler, myk hud, flytende blod, og en komplisert hjerne kan lages ut av denne sammensmeltede cellen. Den trenger å forandre seg, og den kan ikke lage en hel kropp alene.
Det som skjer nå, er nøkkelen til å bli et menneske. Cellen lager en kopi av alt den har fått med seg fra både mor og far. Så fordeler den alt av utstyr og informasjon på to sider og begynner å dele seg i midten. Én celle blir til to. To blir til fire, og raskt deler de seg videre og videre. Snart ligner det nye mennesket på en bringebæraktig celleklump.
Etter hvert begynner cellene å forandre seg. Fra helt like stamceller som kan bli til alt i kroppen, blir de til spesialister som kan gjøre forskjellige oppgaver.
Noen skal sørge for at kroppen får i seg næring fra mat, noen skal ta over styringen og sørge for at kroppens ulike deler «snakker» sammen, andre skal bidra til å holde kroppen samlet og gjøre det mulig å bevege seg.
Når en jente blir
født, har hun allerede med seg alle eggene sine. Det betyr at egget som ble til deg, allerede var inne i moren din da hun lå i magen til mormoren din.
Befruktet eggcelle og en sædcelle – forstørret 1200 ganger. Sædcellen slipper ikke inn i eggcellen fordi den allerede er befruktet av en annen sædcelle. De to runde områdene inne i egget er arvestoffet fra mor og far, som skal kopieres og fordeles når cellen begynner å dele seg.
Etter fem dager har det befruktede egget delt seg så mange ganger at det har blitt til hundrevis av celler. Det ligner på en liten kule som er fylt med væske, og kalles blastocyst. Allerede nå har cellene fått ulike roller: Innerst er det dannet en tett celleklump som skal bli til selve fosteret – altså barnet. Ytterst vokser et tynt lag med celler som har en helt annen oppgave: De fester seg i veggen til livmoren, og begynner å lage morkaken som skal gi næring og oksygen til barnet. Sakte, dag for dag, skal den lille celleklumpen forvandles til et menneske.
Omtrent en uke etter befruktningen er blastocysten klar til å feste seg i livmoren.


Fra umerkelig til uerstattelig
Etter fem uker er den lille celleklumpen blitt så stor som et riskorn, og er knyttet til en liten sekk med næring – plommesekken. Embryoet har nå en bønneaktig form, og de første organene utvikler seg. Allerede nå begynner det knøttlille hjertet å banke. Når babyen blir født, har hjertet allerede slått over 50 millioner ganger.
Etter seks uker begynner celleklumpen å forme seg.
Hodet er stort i forhold til resten, og små knopplignende utvekster for armer og bein dukker opp.
Første antydninger til øyne, nese, munn og ører blir synlige, og fosteret har begynt å bevege seg – selv om det fortsatt er altfor tidlig å kjenne det for moren.
Etter tolv uker ligner fosteret mer og mer på en liten baby. Fingre og tær er på plass, og små negler vokser frem. Fosteret kan suge på tommelen for å trene
musklene som skal brukes til å spise, og gjøre «pusteøvelser» ved å trekke fostervann inn og ut av lungene – små forberedelser til livet utenfor livmoren.
Plommesekken, som har vært fosterets første «matpakke», forsvinner gradvis, og morkaken tar over jobben med å gi næring og oksygen. Den sørger også for å fjerne avfallsstoffer helt frem til fødselen.
Rundt uke 24 er organene så utviklet at de fleste fostre kan overleve om de blir født for tidlig, selv om de trenger mye medisinsk hjelp. De siste ukene i magen handler mest om finpuss: fett lagres for å holde varmen, og organene modnes. På omtrent
280 dager har kroppen skapt et nytt liv – en utrolig reise fra en knapt synlig celle til et lite menneske som snart skal møte verden.
Øyenfargen bestemmes av små, brunsvarte fargekorn i regnbuehinnen – den fargede delen av øyet vårt. Brune øyne har flest fargekorn og er den vanligste øyefargen i verden. Blå øyne har færrest, mens grønne øyne har litt flere enn blå – og er den sjeldneste. Mengden fargekorn påvirker hvordan lyset spres, og gir dermed øynene ulik farge. Regnbuehinnen har også muskler som styrer pupillen: I sterkt lys trekker ringmuskelen seg lynraskt sammen, og gjør pupillen liten.
Når vi blir skremt, slipper kroppen ut adrenalin som gjør at pupillene utvider seg, slik at vi lettere kan få med oss det som skjer.
Regnbuehinnen er unik for hver person. Den har over 200 forskjellige detaljer.
Fingeravtrykk har bare rundt 50. Derfor er skanning av regnbuehinnen en sikrere metode for å identifisere folk enn fingeravtrykk.
Øyets regnbuehinne. ►

Hodelus er en av de vanligste parasittene på mennesker i Norge. Parasitter lever av å snylte på næring fra andre. Hodelusa bor i håret og lever av blod fra hodebunnen. Luer og puter byr ikke på varme eller blod, så her overlever de ikke særlig lenge.
Det er spyttet til lusene som gjør at hodebunnen begynner å klø. Lus sprer seg lett selv om de verken kan hoppe eller fly. De er nemlig lynraske krabbere. Når to hoder er sammen, trenger lusa bare noen sekunder på å klatre fra et hårstrå til et annet. Barnelek, en felles selfie eller en god klem gir lusa muligheten til å flytte over til et nytt hjem.


Tennene er en del av skjelettet, men regnes ikke som bein. Allerede før vi blir født, begynner de å utvikle seg. Gjennom livet setter matvaner, skader og slitasje sine spor, og gjør tennene våre enda mer unike. Derfor kan de spille en viktig rolle i etterforskning for å identifisere ukjente personer. Tennene er dekket av emalje, kroppens hardeste stoff, som er laget for å vare et helt liv. Tennene er så harde at de ofte blir igjen, selv etter en brann eller mange år begravd i jorda.
I Japan kaster de melketenner i lufta eller på bakken, i stedet for å gi dem til tannfeen. Tannen kastes i den retningen den skal vokse, og kastet skal være rett opp eller rett ned for at den nye tannen skal vokse riktig.
Melketann – forstørret 25 ganger. De små sprekkene i tannen er ikke hull, men slitasje. Melketenner har tynnere emalje enn voksentenner og kan derfor lettere få slike sprekker. ►



På 1600-tallet trodde mange at blodet sto stille i kroppen, som vann i et basseng. Det var legen William Harvey som skjønte at blodet renner gjennom kroppen, i en evig rundreise som holder oss i live.
Hver gang hjertet slår, begynner denne reisen på nytt. Først sendes blodet til lungene for å hente oksygen. Deretter tilbake til hjertet, og så langt ut til resten av kroppen. På veien svinger noe av blodet innom tarmene og plukker opp næringsstoffer fra maten – sukker, fett og proteiner. Men før alt dette kan brukes, må blodet innom leveren. Der blir stoffene renset, omdannet og sendt videre i riktig form og mengde. Først da kan cellene ta imot og bruke det. De trekker ut næringsstoffer, byggesteiner og oksygen som kroppen bruker til å tenke, vokse og reparere det som er ødelagt.
Blodet er fylt med mange forskjellige celler som har en rekke livsviktige oppgaver. De frakter energi og næring, reparerer, og forsvarer kroppen mot sykdommer. Røde blodceller frakter oksygen, som gir cellene energi til å gjøre sine oppgaver. Plasma – væsken som blodcellene flyter i – bringer blant annet næring dit det trengs. Når vi skjærer oss, rykker blodplatene ut som kroppens akutt-team. De tetter igjen åpningen lynraskt for å hindre at vi mister for mye blod.
På 1800-tallet, da man begynte å studere blodet i
mikroskop, så man at de fleste blodcellene var røde. Men noen var nesten gjennomsiktige, og ble kalt «hvite». De hvite blodcellene patruljerer gjennom hele kroppen og oppdager trusler som virus og bakterier. Selv om de hvite cellene bare er én prosent av blodcellene, finnes det milliarder av dem – en usynlig innsatsstyrke som holder kroppen trygg.
Immunforsvaret lærer og tilpasser seg hele tiden. Enkelte hvite blodceller – minneceller – husker tidligere infeksjoner, slik at kroppen raskt kan forsvare seg hvis den møter de samme virusene eller bakteriene på nytt. Dette gir oss bedre beskyttelse mot samme sykdom senere. Når vi blir vaksinert, lærer immunforsvaret hvordan det skal slåss mot en bestemt sykdom, og det kan huske sykdommen i mange år. Dette har reddet millioner av liv.
I 1930 fikk Karl Landsteiner nobelprisen fordi han oppdaget at mennesker har forskjellige blodtyper. Feil blodtype kan føre til at immunforsvaret angriper det nye blodet. Valg av riktig blodtype kan derfor avgjøre om en blodoverføring redder liv – eller er dødelig.
Røde og hvite blodceller – forstørret 5200 ganger.


Se menneskekroppen på en helt ny måte.

Du består av 37 tusen milliarder levende byggeklosser – små celler som jobber dag og natt. De gjør at du kan danse, løpe, drømme og snakke. Når cellene samarbeider, lager de alt fra fingernegler og øyevipper til følelser som glede og sinne. I denne boka får du utforske denne utrolige verdenen på nært hold. Bli kjent med cellene og organene, og finn ut hvordan de samarbeider for å bygge og vedlikeholde en imponerende verden av liv: deg.
Boka er skrevet av to prisvinnende forskere og formidlere. Bildene er tatt med flere ulike teknikker, som lar oss komme tett på tenner, øyne, blod, virus – og ikke minst begynnelsen på et nytt menneske.
praktbok for hele familien.